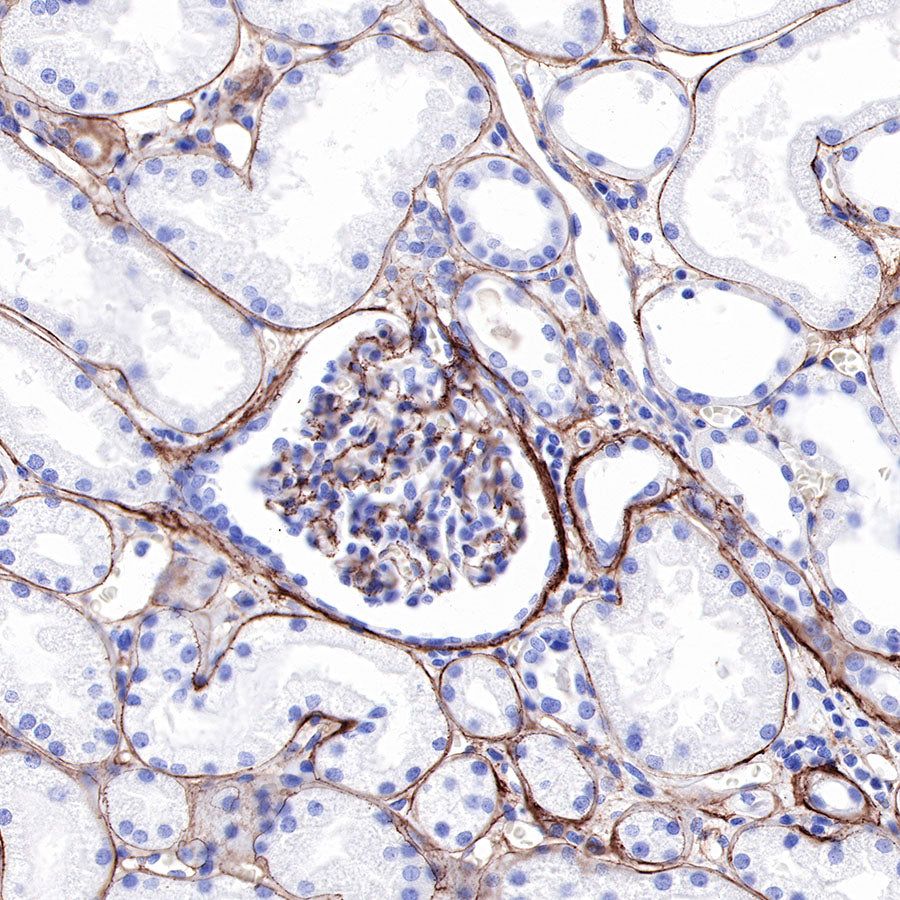
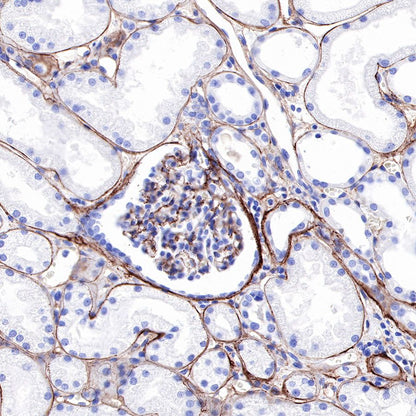

IHC shows positive staining in paraffin-embedded human cardiac muscle. Anti-Collagen IV antibody was used at 1/1000 dilution, followed by a HRP Polymer for Mouse & Rabbit IgG (ready to use). Counterstained with hematoxylin. Heat mediated antigen retrieval with Tris/EDTA buffer pH9.0 was performed before commencing with IHC staining protocol.
Product Details
Product Details
Product Specification
Host | Rabbit |
Antigen | Collagen IV |
Synonyms | Collagen alpha-1(IV) chain, COL4A1 |
Immunogen | Recombinant Protein |
Location | Secreted, Extracellular space, Extracellular matrix |
Accession | P02462 |
Clone Number | SDT-150-49 |
Antibody Type | Rabbit mAb |
Application | IHC-P, IF |
Reactivity | Hu |
Purification | Protein A |
Concentration | 0.25 mg/ml |
Physical Appearance | Liquid |
Storage Buffer | PBS, 40% Glycerol, 0.05%BSA, 0.03% Proclin 300 |
Stability & Storage | 12 months from date of receipt / reconstitution, -20 °C as supplied |
Dilution
application | dilution | species |
IHC-P | 1:1000 | null |
IF | 1:1000 | null |
Background
Collagen alpha-1(IV) chain (COL4A1) is a protein that in humans is encoded by the COL4A1 gene on chromosome 13. It is ubiquitously expressed in many tissues and cell types. COL4A1 is a subunit of the type IV collagen and plays a role in angiogenesis. Mutations in the gene have been linked to diseases of the brain, muscle, kidney, eye, and cardiovascular system. The COL4A1 gene also contains one of 27 SNPs associated with increased risk of coronary artery disease.
Picture
Picture
Immunohistochemistry


IHC shows positive staining in paraffin-embedded human kidney. Anti-Collagen IV antibody was used at 1/1000 dilution, followed by a HRP Polymer for Mouse & Rabbit IgG (ready to use). Counterstained with hematoxylin. Heat mediated antigen retrieval with Tris/EDTA buffer pH9.0 was performed before commencing with IHC staining protocol.

IHC shows positive staining in paraffin-embedded human lung adenocarcinoma. Anti-Collagen IV antibody was used at 1/1000 dilution, followed by a HRP Polymer for Mouse & Rabbit IgG (ready to use). Counterstained with hematoxylin. Heat mediated antigen retrieval with Tris/EDTA buffer pH9.0 was performed before commencing with IHC staining protocol.
Immunofluorescence

IF shows positive staining in paraffin-embedded human kidney. Anti-Collagen IV antibody was used at 1/1000 dilution (Green) and incubated overnight at 4°C. Goat polyclonal Antibody to Rabbit IgG - H&L (Alexa Fluor® 488) was used as secondary antibody at 1/1000 dilution. Counterstained with DAPI (Blue). Heat mediated antigen retrieval with Tris/EDTA buffer pH9.0 was performed before commencing with IF staining protocol.